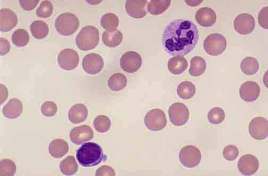
先天性红血球紫质缺乏症

紫质

迷死氧
图片尺寸570x428
布料2021紫色小样各种紫质色卡本鸢示册服装册展尾海绵垫
图片尺寸800x800
汪琴20140925 比较结果 斑点 - 紫质_2345看图王.jpg
图片尺寸3006x3960
先天性红血球紫质缺乏症
图片尺寸268x176
地面上生长的紫质火箭筒底模糊的宏观照片背景图片
图片尺寸450x300
visia紫质图,这真是我见过最油的了!全都 - 抖音
图片尺寸892x670
visia紫质对比:化妆后的皮肤上有很多杂质;卸妆后,杂质彻底消失,但
图片尺寸6922x5184
卟啉病,也被成为血紫质症(porphyria) 卟啉病作为一类显性遗传疾病,在
图片尺寸640x512
视紫质全称"视网膜紫质"(rhodopsin),呈红紫色并因此得名(平行于细胞
图片尺寸720x702
紫质1%—3%,荧光剂残留
图片尺寸570x689
氯化血红素(hemin)为一种含铁卟啉,由原紫质ix和一颗三价铁离子构成
图片尺寸288x279
铁原紫质氯化物
图片尺寸300x300
乳苣——紫质孤芳
图片尺寸750x1336
乳苣——紫质孤芳
图片尺寸750x1336
乳苣——紫质孤芳
图片尺寸750x1336
皱纹,纹理,紫外线色斑,毛孔,棕色斑,红色区,紫质等8个角度来进行分析
图片尺寸640x372
功能:检测斑点,皱纹,纹理,毛孔,紫外线斑,棕色斑,皮肤炎症,紫质卟啉
图片尺寸480x639
visia皮肤检测38岁
图片尺寸1080x1439
剂,能够有效缓解睫状肌的紧张性,并促进视网膜细胞中的视 紫质的再生
图片尺寸1080x675
skin test analysis machine / 3d professional skin
图片尺寸439x582